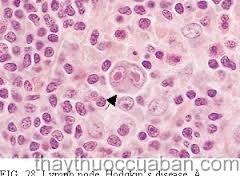
Tăng sinh mô ác tính

Tăng sinh mô ác tính
Chế độ ăn uống kiêng kị cho bệnh nhân ung thư
Bài thuốc gia truyền chữa ung thư phổi
Theo Trung Quốc danh phương toàn tâp dùng bài: " Ngưu hoàng thanh cung
đan" (Trung quốc trung dược thành dược xử
phương tập)
Theo Trung Quốc danh phương toàn tâp dùng bài: " Ngưu hoàng thanh cung
đan" (Trung quốc trung dược thành dược xử
phương tập)
| Ngưu hoàng thanh cung đan | Ngân hoa | 20 | Hoàng cầm | 10 | Hoa phấn | 10 | |
| Đại hoàng | 10 | Tê giác | 10 | Liên kiều | 6 | Huyền sâm | 4 |
| Xạ hương | 0.1 | Băng phiến | 2 | Mạch đông | 10 | Liên tử tâm | 10 |
| Cam thảo | 10 | Sinh chi tử | 10 | Sinh địa | 6 | Quảng uất kim | 6 |
| Chu sa | 8 | Ngưu hoàng | 0.1 | Hùng hoàng | 11 | ||
Cách dùng. Các vị luyện mật làm hoàn, ngày uống 2 gam.
Công dụng. thanh nhiệt giải độc dưỡng âm,.
********************************




|
Bài viết đã được đăng ký bản quyền (DMCA). Nếu copy nội dung hãy để lại link về bài gốc như một sự tri ân với tác giả. Xin cảm ơn!
Thông tin trên Website :www.thaythuoccuaban.com chỉ có tính chất tham khảo. Người xem không được dựa vào để tự chữa bệnh.
Lương y Nguyễn Hữu Toàn . Địa chỉ: Số 482 lô 22C Đường Lê Hồng Phong, Đông Khê, Ngô Quyền, Hải Phòng. GP : 197GCN HNY SYTH

